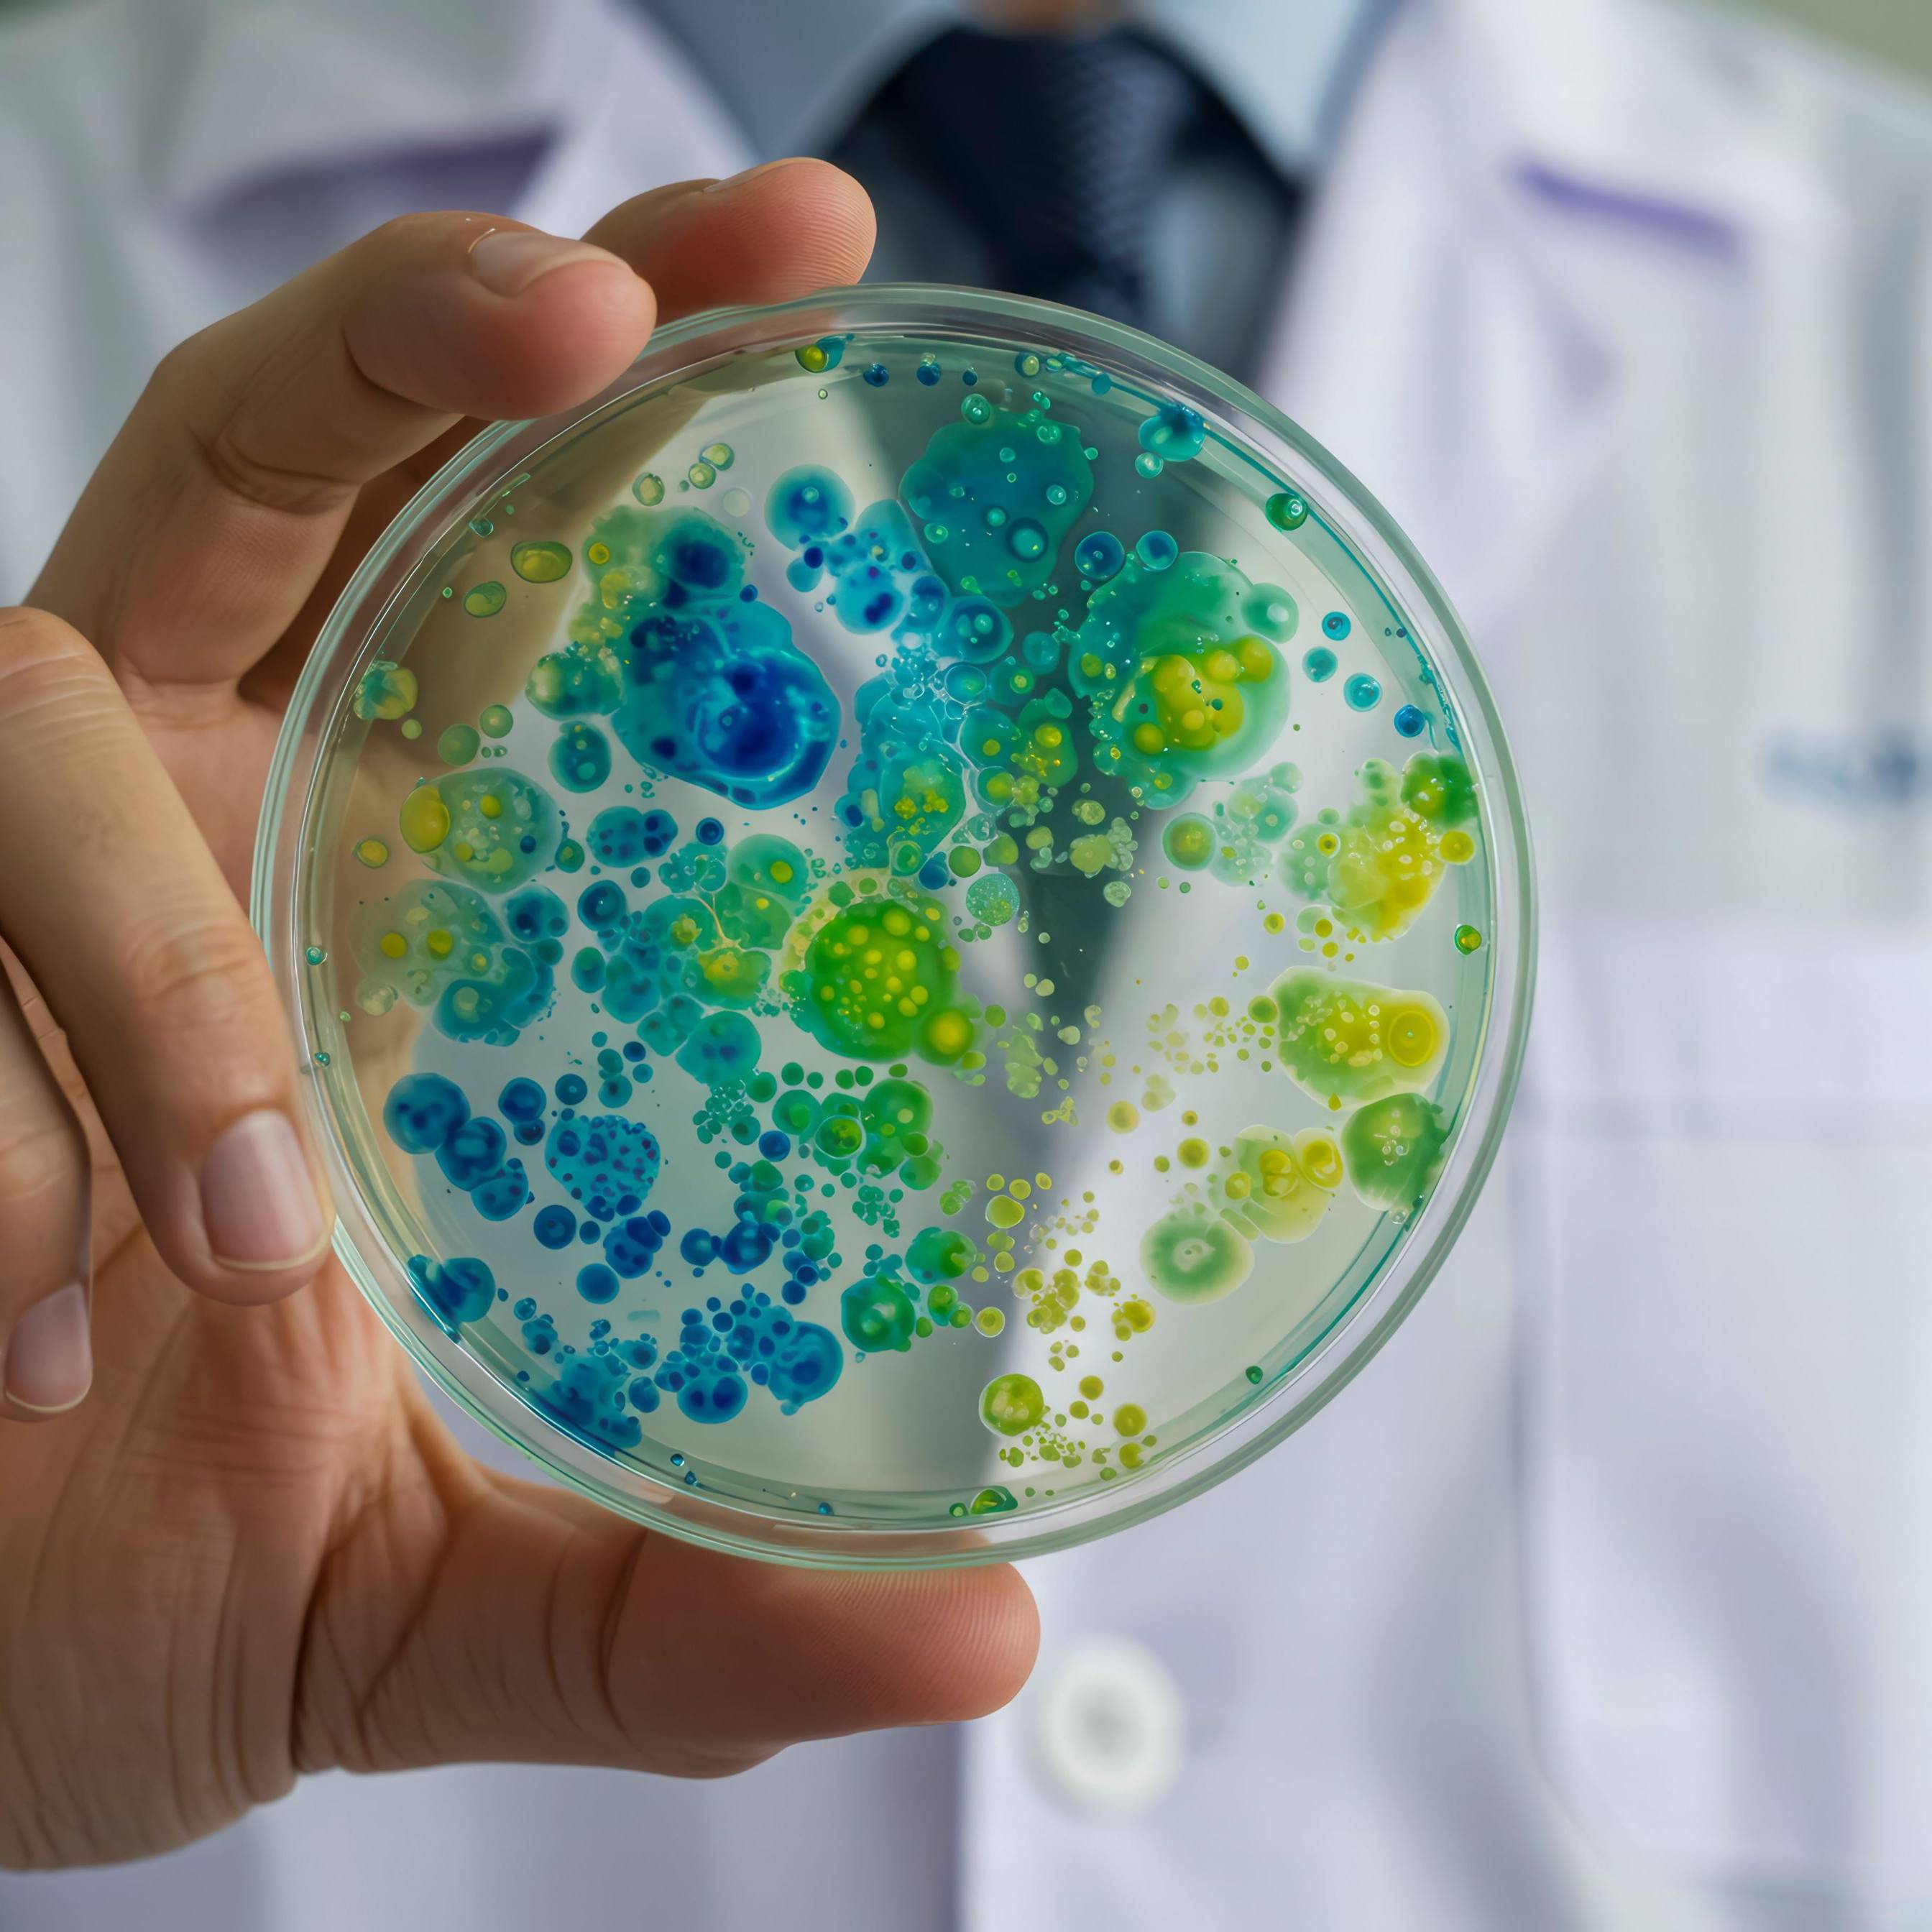

TREND FIVE:
BIOLOGY-INSPIRED INNOVATION ASSET MAINTENANCE
According to the Canadian academic and science broadcaster David Suzuki, “In nature there is no such thing as waste.” Natural systems operate in closed loops, where every output becomes a resource for something else. Drawing inspiration from this principle, innovators are developing technologies that mimic nature’s efficiency – transforming waste into valuable inputs for new products.
Whether by replicating the structural logic of biological forms or harnessing the power of microbes to upcycle discarded materials, these solutions are helping to reduce resource consumption and emissions. By turning waste into a design opportunity, they are laying the groundwork for a more circular and regenerative economy.
INNOVATION ONE:
Using biomimicry for more sustainable materials
Manufacturing in a way that aligns with net-zero goals will require more responsible choices in raw materials, as well as smarter and more efficient designs. With this in mind, French startup MODULATIO turned to nature for inspiration for materials that are lighter and use fewer resources, while still retaining the desired strength.
Similar to honeycombs or reticular structures (net-like structures like those found in the lungs), MODULATIO moulds products using just the right amount of material, and only where it is actually needed. The startup refers to its patented solution as ‘Moulding alveolar and lattices structures with [a] variation in density’, meaning the final material is not completely solid, but rather made up of a rigid web of material with gaps of air.
It can achieve the same mechanical properties with three times fewer resources.”

Designing materials in this way means MODULATIO’s products consume fewer natural resources and are ultimately much lighter, making them easier and less emissions intensive to transport. According to the company, it can achieve the same mechanical properties with three times fewer resources, and its products can be made from a variety of resources depending on the end customer’s needs. Plus, the unique structure gives MODULATIO products other appealing qualities, including heat or sound insulation, shock absorbance, and easy drainage.
The startup’s materials have a wide range of potential applications across industrial production and construction. These could include shoe soles, aircraft, green living walls, and flood-resistant pavements. MODULATIO’s technology is also compatible with traditional steel reinforcements, meaning it could be easily used to create concrete beams with a much lower volume of carbon-intensive concrete mix.
TAKEAWAYS:
- Inspired by nature, MODULATIO moulds products with lattice structure that use just the right amount of material
- Designing materials in this way means MODULATIO’s products consume fewer natural resources and are much lighter
- The materials have a wide range of potential applications across industrial production and construction
INNOVATION TWO:
A microbial library to make ingredients from waste
According to the United Nations Environmental Programme, food loss and waste account for as much as 8 to 10 per cent of global greenhouse gas emissions, with this waste happening across the entire value chain. Biotech company Fermenstation has one solution.
The startup is hoping to reduce this waste and shift away from the linear use of resources by using fermentation technology to transform food waste into new ingredients. To achieve this, the company leverages a database of the characteristics of underutilised biomass, enzymes, and non-GMO microorganisms to create new products.
The company’s database includes information that enables it to choose the most efficient waste materials and microbes to create new ingredients with high concentrations of target compounds and minimal impurities. Types of components that can be manufactured include ingredients that enhance aroma and richness or add functionality for health and beauty applications.
The company’s database includes information that enables it to choose the most efficient waste materials and microbes to create new ingredients with high concentrations of target compounds and minimal impurities.”
A member of the Fermenstation team told Springwise that the company was “founded with the goal of balancing business viability with social impact. We believe that in the face of limited resources, a growing population, and climate change, it is essential to utilise the vast amount of discarded resources. Our desire to develop the necessary technologies and bring them to market is what drives our work.”
The company’s ingredients are already being used in food, beverages, and cosmetics. Fermenstation also collaborates with major corporations, research institutions and local communities to integrate sustainable circularity into product development, preventing food byproducts from going to waste.
TAKEAWAYS:
- Fermenstation leverages a database of the characteristics of underutilised biomass, enzymes, and non-GMO microorganisms to create new products
- This database enables the startup to choose the most efficient waste materials and microbes to create ingredients with high concentrations of target compounds
- The company’s ingredients are already being used in food, beverages, and cosmetics.